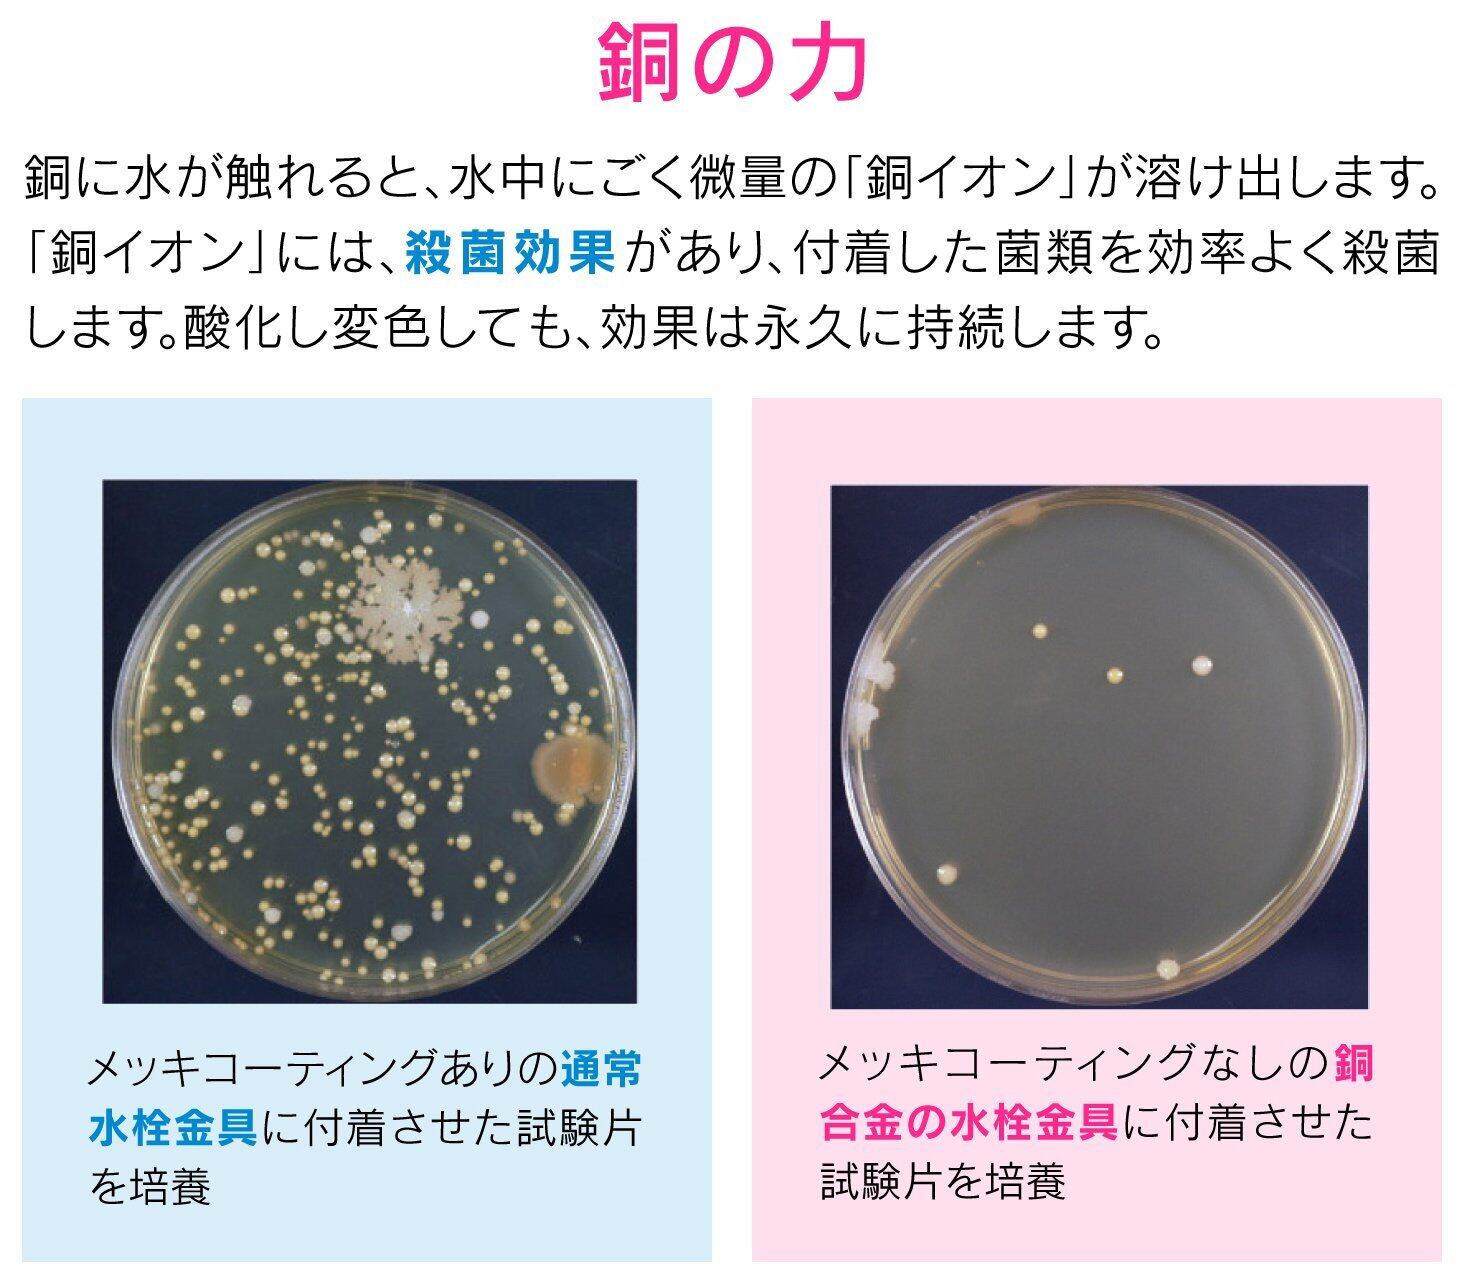

・翌月にまとめてお支払い可能
・手数料無料(口座振替の場合)
・アプリでご利用金額を確認できて安心

¥4,649 税込
残り1点
なら 手数料無料の 翌月払いでOK
この商品は送料無料です。
【商品名】
ガオナ これカモ シンク用 銅製ゴミカゴ 排水口のゴミ受け (殺菌効果 ヌメリ・臭い防止 衛生的) GA-PB012
【サイズ】
パターン名:ゴミカゴのみ
【商品説明】
直径:144ミリ×高さ:44.5ミリ
素材・材質:銅
生産国:日本
使用を重ねるうちに黒ずんでいき、しだいに薄青みがかった皮膜に変色しますが、銅イオンの殺菌効果は変わりません。
送料・配送方法について
お支払い方法について